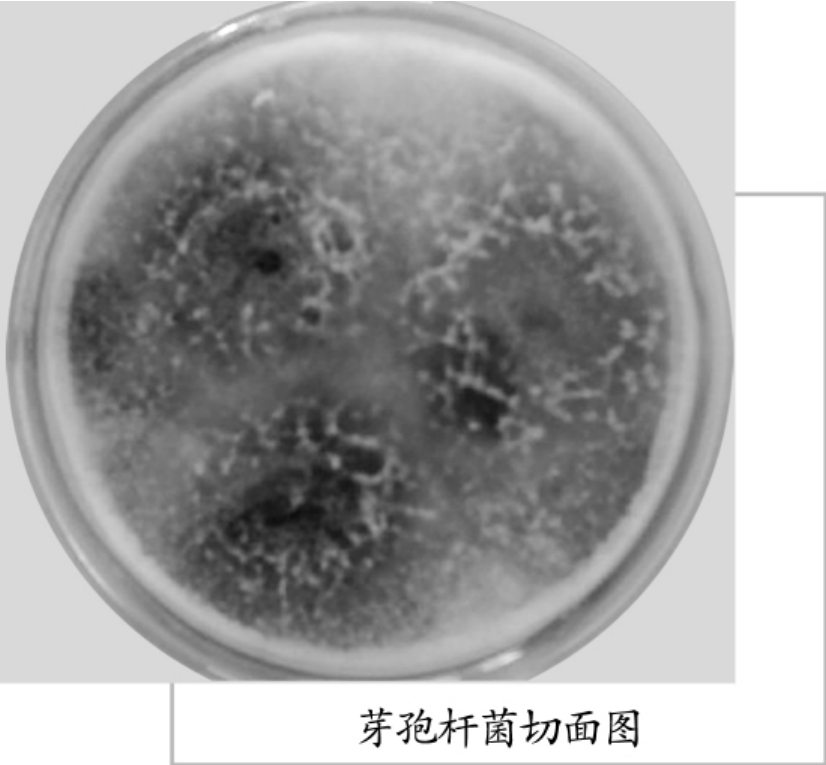
img122

显微镜下的微生物世界
-
1.1前 言
-
1.2第一章 认识微生物世界
-
1.2.1微生物的概念和种类
-
1.2.2微生物的重要性
-
1.2.3微生物的应用前景
-
1.2.4微生物细胞的化学组成
-
1.2.5微生物的营养物质
-
1.2.6微生物的营养类型
-
1.2.7微生物的分布
-
1.2.8微生物的应用
-
1.2.9微生物与环境
-
1.2.10微生物对污染物的降解与转化
-
1.2.11微生物与重金属的转化
-
1.2.12污染介质的微生物处理
-
1.2.13污染环境的生物修复
-
1.2.14生态环境与微生物监测
-
1.3第二章 水中的微生物
-
1.3.1草履虫
-
1.3.2大肠杆菌
-
1.3.3蓝 藻
-
1.3.4绿 藻
-
1.3.5硅 藻
-
1.3.6沙门菌
-
1.3.7变形虫
-
1.3.8放线菌
-
1.3.9菌胶团
-
1.3.10粪链球菌
-
1.3.11革兰阴性菌
-
1.3.12弧 菌
-
1.3.13铁细菌
-
1.3.14原 虫
-
1.3.15产气荚膜梭菌
-
1.3.16伤寒杆菌
-
1.3.17痢疾杆菌
-
1.3.18霍乱弧菌
-
1.3.19钩端螺旋体
-
1.4第三章 土壤中的微生物
-
1.4.1磷细菌
-
1.4.2固氮菌
-
1.4.3根瘤菌
-
1.4.4霉 菌
-
1.4.5酵母菌
-
1.4.6子囊菌
-
1.4.7担子菌
-
1.4.8腐生菌
-
1.4.9分生孢子
-
1.4.10毛霉菌
-
1.4.11糖真菌
-
1.4.12硝化细菌
-
1.4.13小单孢菌
-
1.4.14青 霉
-
1.4.15镰刀菌
-
1.4.16根足虫
-
1.4.17纤毛虫
-
1.4.18炭疽杆菌
-
1.5第四章 空气中的微生物
-
1.5.1结核菌
-
1.5.2硫细菌
-
1.5.3醋酸细菌
-
1.5.4白喉杆菌
-
1.5.5葡萄球菌
-
1.5.6溶血性链球菌
-
1.5.7花 粉
-
1.5.8尘 螨
-
1.5.9微球菌属
-
1.5.10芽孢杆菌属
-
1.5.11青霉属
-
1.5.12曲霉属
-
1.5.13真菌孢子
-
1.5.14细菌芽孢
-
1.5.15球 菌
-
1.5.16结核杆菌
-
1.5.17百日咳杆菌
-
1.5.18肺炎支原体
-
1.6第五章 食物中的微生物
-
1.6.1黑曲霉
-
1.6.2好食脉孢菌
-
1.6.3黑根霉
-
1.6.4芽孢杆菌
-
1.6.5阴沟肠杆菌
-
1.6.6梭状芽孢杆菌
-
1.6.7黄杆菌
-
1.6.8链球菌
-
1.6.9巨大芽孢杆菌
-
1.6.10肉毒杆菌
-
1.6.11乳酸菌
-
1.6.12弯曲杆菌
-
1.6.13荧光假单胞菌
-
1.6.14醋酸杆菌
-
1.6.15志贺菌
-
1.7第六章 显微镜下的人体病毒
-
1.7.1病原体
-
1.7.2流感病毒
-
1.7.3天花病毒
-
1.7.4狂犬病毒
-
1.7.5埃博拉病毒
-
1.7.6禽流感病毒
-
1.7.7甲型H1N1病毒
-
1.7.8艾滋病毒
-
1.7.9麻疹病毒
-
1.7.10腮腺炎病毒
-
1.7.11风疹病毒
-
1.7.12肠道病毒71型
-
1.7.13轮状病毒
-
1.7.14甲型肝炎病毒
-
1.7.15乙型肝炎病毒
-
1.7.16丙型肝炎病毒
-
1.7.17登革病毒
-
1.7.18森林脑炎病毒
-
1.7.19汉坦病毒
-
1.8第七章 人体内的寄生虫
-
1.8.1斯氏狸殖吸虫
-
1.8.2棘口科吸虫
-
1.8.3日本血吸虫
-
1.8.4布氏姜片吸虫
-
1.8.5卫氏并殖吸虫
-
1.8.6异形吸虫
-
1.8.7华支睾吸虫
-
1.8.8艾氏小杆线虫
-
1.8.9美丽筒线虫
-
1.8.10旋毛形线虫
-
1.8.11班氏丝虫
-
1.8.12鞭 虫
-
1.8.13蛲 虫
-
1.8.14蛔 虫
-
1.8.15钩 虫
-
1.8.16缩小膜壳绦虫
-
1.8.17细粒棘球绦虫
-
1.8.18曼氏迭宫绦虫
-
1.8.19猪带绦虫
-
1.8.20牛带绦虫
-
1.8.21疟原虫
-
1.8.22丝 虫
-
1.8.23肺吸虫
-
1.8.24弓形虫
-
1.8.25疥 螨
-
1.8.26肝吸虫